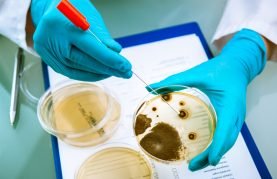
Post - 3

Nosso Blog
Blog da SP Labor
Dicas e Novidades - Sua Fonte de Conhecimento em Equipamentos e Tecnologia para Laboratório.
Laboratório de Microbiologia
Categorias
15 mar 2026
Capela de Fluxo Laminar: o que é, como funciona e como escolher Em um laboratório, um erro invisível pode comprometer todo um resultado. A contaminação...
18 fev 2024
Como Montar Um Laboratório de Microbiologia? Saiba Mais Você já se perguntou como é possível detectar a presença de microrganismos em alimentos, água e outros...
13 maio 2021
O que é um Laboratório de Microbiologia de Alimentos? Um Laboratório de Microbiologia de Alimentos é uma estrutura especializada responsável por analisar a presença de...
1 nov 2017
O que é um meio de cultura? Qual a sua importância e classificação? Um meio de cultura é uma substância ou ambiente no qual...